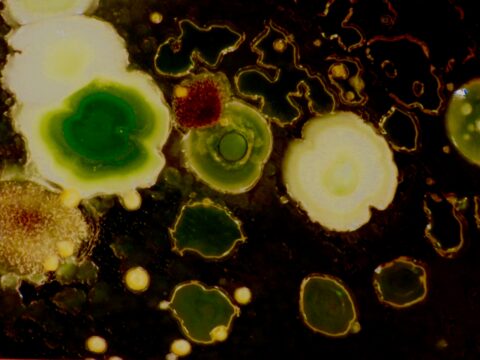
Snug with Your Bugs? How Microbes Control Your Sleep

Category: Health and Wellness
Can Oral Bacteria Make Heart Disease Worse?
Understanding the Connection Between Oral Health and Heart Disease The relationship between oral health and heart disease has garnered considerable attention in recent years, leading…
One Simple Dental Change That Could Help Reduce Your Risk of Dementia
Understanding the Connection Between Oral Health and Dementia Recent research has begun to illuminate the intricate relationship between oral health and dementia, with a particular…
Understanding Pain: Insights from Sanjay Gupta on Why ‘It Doesn’t Have to Hurt’
The Nature of Pain Pain is a complex and multifaceted experience that serves as a critical protective mechanism for the body. Biologically, pain functions as…
The Right Way to Check Blood Pressure: Common Mistakes and How to Avoid Them
Understanding Blood Pressure Basics Blood pressure is a critical physiological parameter that measures the force exerted by circulating blood against the walls of blood vessels….
Understanding Kissing Bug Disease: The Growing Threat in the U.S.
What Are Kissing Bugs and Their Connection to Disease? Kissing bugs, belonging to the Triatominae subfamily, are insects predominantly found in the Americas, with a…
Snug with Your Bugs? How Microbes Control Your Sleep
Introduction: The Sleep-Microbe Connection The human microbiome refers to a complex ecosystem of trillions of microorganisms, including bacteria, viruses, fungi, and protozoa, residing primarily in…